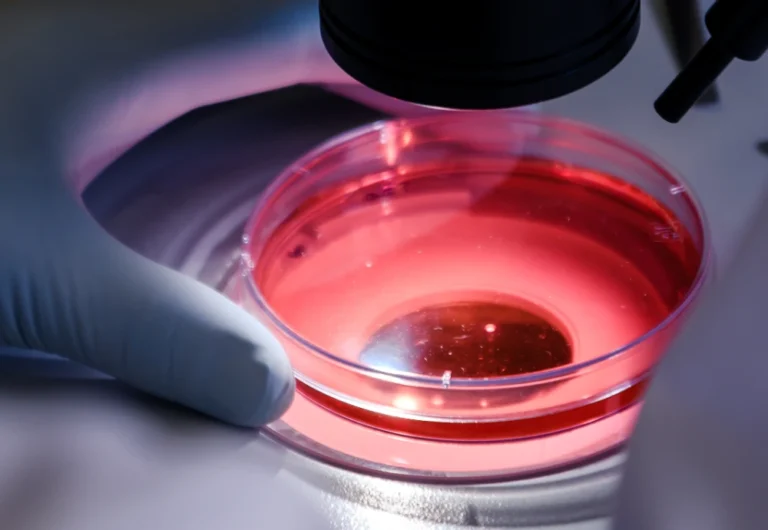

-
Shop
- Adidas
- Advanced Technologies
- Apple Accessories
- Best-Sellers
- Calvin Klein
- Car Accessories
- Dating & Social Skills
- Denim
- 7FOR
- AGOLDE
- Antony Morato
- Armani Exchange
- Boss
- Brunello Cucinelli
- Calvin Klein Jeans
- Costume National
- Desigual
- Diesel
- Dolce & Gabbana
- Dsquared²
- Ermanno Scervino
- Fendi
- Gianni Lupo
- Guess Jeans
- Ichi
- Just Cavalli
- Lee
- Levi's
- Liu Jo
- Morgan De Toi
- Mother Denim
- Only
- Pepe Jeans
- Pinko
- Replay
- Tommy Hilfiger Jeans
- Valentino
- Vero Moda
- Education & Learning
- Family & Parenting
- Fashion
- Fashion Accessories
- Furniture
- Gadgets
- Garden Supplies
- Health & Beauty
- Health & Wellness
- Home & Garden
- Home Supplies
- Independence Day
- Kids & Babies
- Lighting
- Patio, Lawn & Garden
- Personal Growth
- Pet Care
- Pet Supplies
- Pets
- Road Trip Accessories
- Samsung Accessories
- Shoes
- Sport & Outdoors
- Super Deals
- Tesla Accessories
- Travel
- Wealth
Read more
(150)
Load More Articles